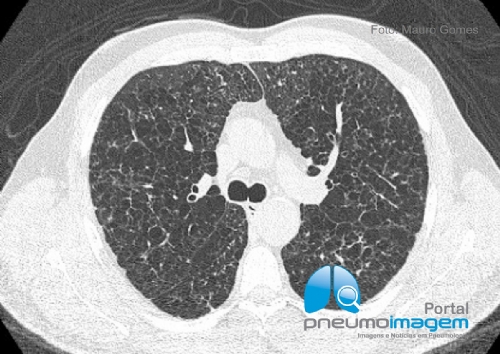
CASO CL�NICO #56

- 27 de Abril de 2026 - Segunda
Casos Clínicos
CASO CLÍNICO #56PESQUISA DE IMAGENS
- ABSCESSO PULMONAR
- ANATOMIA RADIOLÓGICA
- ASMA
- BRONQUIECTASIAS
- BRONQUIOLITES
- DIVERSOS
- DOENÇA DO REFLUXO GASTRESOFÁGICO
- DOENÇAS FÚNGICAS
- DOENÇAS INTERSTICIAIS
- DOENÇAS OCUPACIONAIS
- DOENÇAS PLEURAIS
- DOENÇAS VASCULARES
- DPOC
- METÁSTASES
- MICOBACTERIOSES NÃO-TUBERCULOSAS
- NEOPLASIAS
- NÓDULOS
- OUTROS ÓRGÃOS
- PNEUMONIAS
- TUBERCULOSE
- VIAS AÉREAS SUPERIORES
CASO CLÍNICO #56
Homem de 48 anos, tabagista e que se apresenta com dispneia. Qual o diagnóstico? Deixe seus comentários abaixo.
Homem de 48 anos, tabagista e que se apresenta com dispneia. Qual o diagnóstico? Deixe seus comentários abaixo.***
A 48-year-old male smoker with dyspnoea. What is the diagnosis? Write your comments below.
Resposta
Veja a resposta /See the answer
Clique aqui / Click here



2 COMENTÁRIOS
Marcelo dos Santos Sampaio
MFC e pneumologia
São Paulo - Sp - 03/05/2019 23:04Ricardo delduque
Pneumologia
Catanduva - São paulo - 03/05/2019 01:10DEIXE SEU COMENTÁRIO